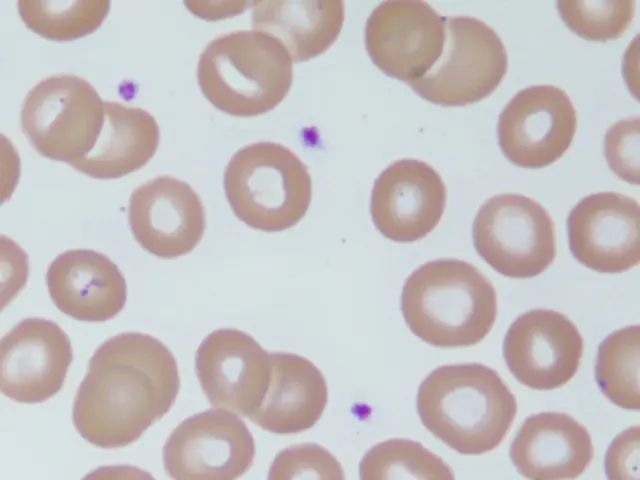
Erythrozyten im Blutbild: Bedeutung, Werte und mögliche Erkrankungen - Was bedeutet ERY im Bluttest ery blutbild - Was bedeutet ERY im Bluttest

Das Blutbild ist ein wichtiger Bestandteil der medizinischen Diagnostik und liefert wertvolle Informationen über die Zusammensetzung und Funktion des Blutes. Ein wichtiger Bestandteil des Blutbildes sind die Erythrozyten, auch bekannt als rote Blutkörperchen. Diese Zellen spielen eine entscheidende Rolle im Sauerstofftransport und sind essenziell für die Funktion des Körpers. In diesem Artikel befassen wir uns mit dem Erythrozyten-Wert im Blutbild, seiner Bedeutung, den möglichen Ursachen für Abweichungen von den Normwerten und den Folgen für die Gesundheit.
Was sind Erythrozyten und warum sind sie wichtig?
Erythrozyten sind kleine, scheibenförmige Zellen, die den größten Teil des Blutes ausmachen. Sie werden im Knochenmark gebildet und haben eine Lebensdauer von etwa 120 Tagen. Ihre wichtigste Aufgabe ist der Sauerstofftransport vom Herzen zu den Organen und Geweben des Körpers.
Die Erythrozyten sind reich an Hämoglobin, einem roten Blutfarbstoff, der die Fähigkeit besitzt, Sauerstoff zu binden. Wenn das Blut durch die Lunge fließt, nimmt das Hämoglobin Sauerstoff auf und transportiert ihn anschließend zu den Organen und Geweben. Dort wird der Sauerstoff abgegeben, um die Zellen mit Energie zu versorgen.
Die Anzahl der Erythrozyten im Blut ist ein wichtiger Indikator für die Sauerstoffversorgung des Körpers. Ein Mangel an Erythrozyten kann zu einer Anämie führen, einer Erkrankung, die durch eine unzureichende Sauerstoffversorgung des Körpers gekennzeichnet ist.
Erythrozyten im Blutbild: Normwerte und Interpretation
Die Anzahl der Erythrozyten im Blut wird in einem Blutbild bestimmt. Die Normwerte für Erythrozyten können je nach Alter, Geschlecht und Labor leicht variieren. Im Allgemeinen gelten folgende Werte als normal:
Normwerte für Erythrozyten:
| Geschlecht | Untergrenze (Millionen/µl) | Obergrenze (Millionen/µl) |
|---|---|---|
| Männer | 4,3 | 5,7 |
| Frauen | 3,9 | 5,3 |
Wichtig: Die genannten Werte sind nur Richtwerte. Es ist wichtig, dass die Erythrozyten-Werte im Kontext des gesamten Blutbildes und der individuellen Krankengeschichte betrachtet werden.
Erhöhte Erythrozyten: Ursachen und Folgen
Ein erhöhter Erythrozyten-Wert kann auf verschiedene Ursachen zurückzuführen sein. Einige häufige Ursachen sind:
- Dehydration (Austrocknung): Bei Dehydration wird das Blutvolumen reduziert, was zu einer scheinbaren Erhöhung der Erythrozyten-Anzahl führt.
- Polycythaemia vera: Bei dieser Erkrankung werden im Knochenmark zu viele Blutzellen produziert, darunter auch Erythrozyten.
- Hoher Lebensstand: Menschen, die in großer Höhe leben, haben oft einen erhöhten Erythrozyten-Wert, da der Körper sich an den geringeren Sauerstoffgehalt in der Luft anpasst.
- Rauchen: Rauchen kann ebenfalls zu einem erhöhten Erythrozyten-Wert führen.
- Lungenkrankheiten: Bei chronischen Lungenerkrankungen wie COPD kann der Körper versuchen, den Sauerstoffmangel durch eine erhöhte Produktion von Erythrozyten zu kompensieren.
- Herz-Kreislauf-Erkrankungen: In einigen Fällen kann ein erhöhter Erythrozyten-Wert auch ein Zeichen für eine Herz-Kreislauf-Erkrankung sein.
Ein erhöhter Erythrozyten-Wert kann zu folgenden Symptomen führen:
- Kopfschmerzen
- Schwindel
- Müdigkeit
- Atemnot
- Sehstörungen
- Trombose (Blutgerinnsel)
Wenn Sie einen erhöhten Erythrozyten-Wert haben, ist es wichtig, die Ursache zu klären und eine entsprechende Behandlung einzuleiten.
Geringere Erythrozyten: Ursachen und Folgen
Ein niedriger Erythrozyten-Wert wird als Anämie bezeichnet. Anämie kann durch verschiedene Faktoren verursacht werden, darunter:
- Eisenmangel: Eisen ist ein wichtiger Bestandteil von Hämoglobin. Ein Mangel an Eisen kann zu einer verminderten Produktion von Erythrozyten führen.
- Vitamin-B12-Mangel: Vitamin B12 ist ebenfalls essenziell für die Bildung von Erythrozyten.
- Folsäuremangel: Folsäure ist ein wichtiges Vitamin für die Zellteilung und -entwicklung, einschließlich der Bildung von Erythrozyten.
- Chronische Blutverluste: Regelmäßige Blutverluste, beispielsweise durch starke Menstruation, Magen-Darm-Blutungen oder chronische Blutspenden, können zu einem Mangel an Erythrozyten führen.
- Blutkrankheiten: Erkrankungen wie Leukämie oder Myelodysplastisches Syndrom können zu einer verminderten Produktion von Erythrozyten führen.
- Chronische Erkrankungen: Einige chronische Erkrankungen wie Nierenversagen oder chronisch-entzündliche Darmerkrankungen können ebenfalls zu Anämie führen.
Die Symptome einer Anämie können je nach Schweregrad der Erkrankung variieren. Zu den häufigsten Symptomen gehören:
- Müdigkeit
- Schwäche
- Kurzatmigkeit
- Schwindel
- Blässe
- Kopfschmerzen
- Herzklopfen
- Kältegefühl
Wenn Sie Anzeichen einer Anämie haben, ist es wichtig, einen Arzt aufzusuchen, um die Ursache der Anämie zu klären und eine entsprechende Behandlung einzuleiten.
Diagnose und Behandlung von Erythrozyten-Abweichungen
Um die Ursache für einen erhöhten oder erniedrigten Erythrozyten-Wert zu klären, wird der Arzt zunächst ein Blutbild anfordern. Zusätzlich können weitere Untersuchungen erforderlich sein, um die Ursache der Erythrozyten-Abweichung zu identifizieren. Dazu gehören:
- Blutuntersuchungen zur Bestimmung des Hämoglobin-Wertes, des Ferritin-Wertes (Eisenwert) und des Vitamin-B12-Wertes.
- Knochenmarkspunktion zur Untersuchung der Blutbildung im Knochenmark.
- Magenspiegelung oder Darmspiegelung zur Abklärung von Blutungen im Magen-Darm-Trakt.
- Bildgebende Verfahren wie Röntgen, CT oder MRT zur Abklärung von Tumoren oder anderen Erkrankungen.
Die Behandlung von Erythrozyten-Abweichungen hängt von der zugrunde liegenden Ursache ab. Bei Anämie kann die Behandlung beispielsweise die Einnahme von Eisenpräparaten, Vitamin-B12-Präparaten oder Folsäurepräparaten umfassen. Bei einer Polycythaemia vera kann die Behandlung eine Aderlasstherapie oder eine medikamentöse Therapie umfassen.
Häufige Fragen und Antworten
Was bedeutet es, wenn die Erythrozyten erhöht sind?
Ein erhöhter Erythrozyten-Wert kann auf verschiedene Ursachen zurückzuführen sein, darunter Dehydration, Polycythaemia vera, Hoher Lebensstand, Rauchen, Lungenkrankheiten und Herz-Kreislauf-Erkrankungen. Die Symptome können Kopfschmerzen, Schwindel, Müdigkeit, Atemnot, Sehstörungen und Thrombose sein.
Was bedeutet es, wenn die Erythrozyten erniedrigt sind?
Ein niedriger Erythrozyten-Wert wird als Anämie bezeichnet. Die Ursachen für Anämie sind vielfältig, darunter Eisenmangel, Vitamin-B12-Mangel, Folsäuremangel, chronische Blutverluste, Blutkrankheiten und chronische Erkrankungen. Die Symptome können Müdigkeit, Schwäche, Kurzatmigkeit, Schwindel, Blässe, Kopfschmerzen, Herzklopfen und Kältegefühl sein.

Kann ich etwas tun, um meinen Erythrozyten-Wert zu verbessern?
Ja, es gibt verschiedene Möglichkeiten, um die Erythrozyten-Werte zu verbessern. Bei Anämie kann die Einnahme von Eisenpräparaten, Vitamin-B12-Präparaten oder Folsäurepräparaten hilfreich sein. Eine gesunde Ernährung mit viel frischem Obst und Gemüse ist ebenfalls wichtig. Bei Dehydration sollten Sie ausreichend Flüssigkeit zu sich nehmen.

Wann sollte ich einen Arzt aufsuchen?
Wenn Sie Symptome wie Müdigkeit, Schwäche, Kurzatmigkeit, Schwindel, Blässe, Kopfschmerzen, Herzklopfen oder Kältegefühl haben, sollten Sie einen Arzt aufsuchen. Auch bei einem erhöhten Erythrozyten-Wert ist es wichtig, die Ursache abzuklären.
Zusammenfassung
Der Erythrozyten-Wert im Blutbild ist ein wichtiger Indikator für die Sauerstoffversorgung des Körpers. Ein erhöhter oder erniedrigter Erythrozyten-Wert kann auf verschiedene Erkrankungen hinweisen. Es ist wichtig, die Ursache für Erythrozyten-Abweichungen abzuklären und eine entsprechende Behandlung einzuleiten. Eine gesunde Lebensweise mit ausreichend Bewegung, einer ausgewogenen Ernährung und dem Verzicht auf Rauchen kann dazu beitragen, die Erythrozyten-Werte im normalen Bereich zu halten.
Wenn Sie andere Artikel kennenlernen möchten, die Erythrozyten im blutbild: bedeutung, werte & krankheiten ähneln, können Sie die Kategorie Blutbild & anämie besuchen.
